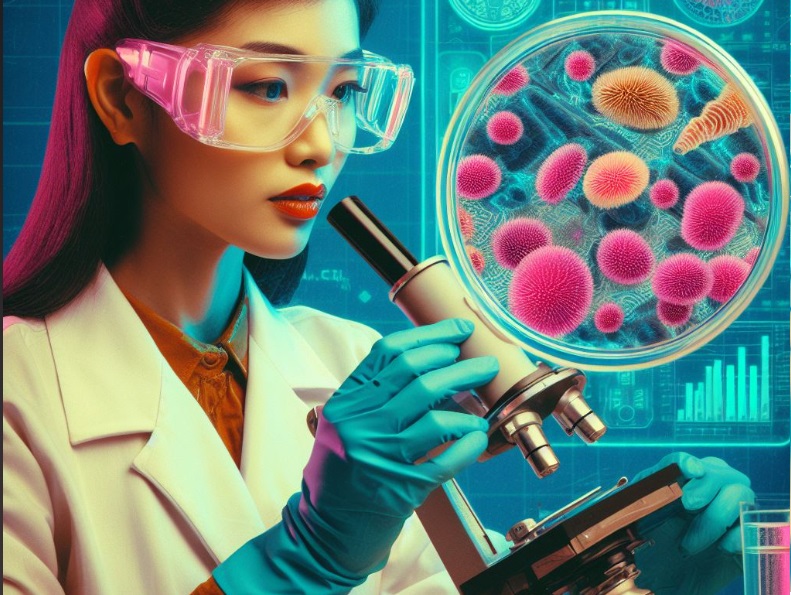

藥物靶點

MET(hepatocyte growth factor receptor,HGF receptor)是受體酪氨酸激酶(RTK),它在細胞生長、增殖、分化和遷移等生物學過程中起重要作用。
查看詳情

單克隆抗體藥物(Monoclonal Antibody Drugs)和靶向藥物(Targeted Therapy)是兩種不同的治療策略,它們在作用方式和應用范圍上存在一些區別。
查看詳情
ADC(Antibody-Drug Conjugate)是由抗體和藥物連接而成的復合物,其中抗體用于特異性識別和結合腫瘤細胞表面的靶點,而藥物則用于殺死或抑制這些細胞。
查看詳情

MSLN (Mesothelin)是膜細胞黏附分子,它在腫瘤發生和進展中發揮著重要的作用,并且被廣泛認為是腫瘤治療的潛在靶標。EGFR (Epidermal
查看詳情

LIF(Leukemia Inhibitory Factor)細胞因子,對于腫瘤的發展和治療具有一定的作用。LIF在人體中通過與其受體結合而發揮生物學功能。
查看詳情
BCMA(B-Cell Maturation Antigen)是一種在B細胞成熟過程中表達的靶點蛋白,它在多發性骨髓瘤(Multiple Myeloma,MM)研究中起到了
查看詳情







對生物樣本的分析,例如蛋白質組學、基因組學和代謝組學等。通過這些技術可以發現與疾病相關的蛋白質,并確定可能的靶點蛋白。以確定藥物與靶點蛋白之間的相互作用方式
查看詳情
CCR2蛋白主要作用是調節單核細胞的遷移和聚集,單核細胞包括單核細胞前體、巨噬細胞和樹突狀細胞等。當組織損傷或感染導致炎癥反應時,CCR2蛋白會被激活并吸引大量單核細胞到炎癥部位
查看詳情












